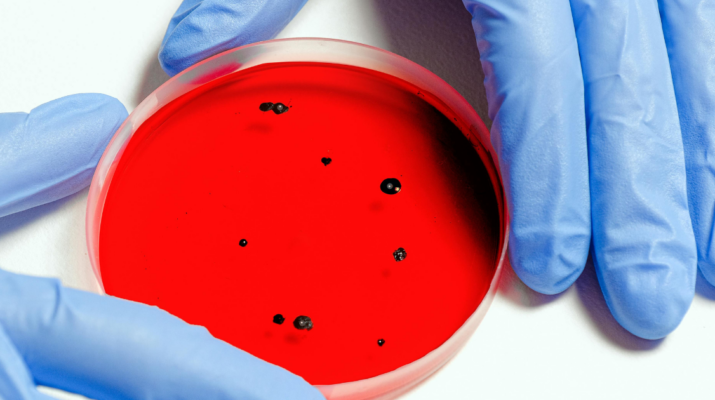

Puebla, 14 de enero. La Secretaría de Salud (SS) federal está investigando la posible presencia del virus metapneumovirus humano (HMPV) en un hombre de 53 años que falleció recientemente en Puebla. El titular de la SS, David Kershenobich Stalnikowitz, mencionó en la conferencia de prensa matutina de la presidenta Claudia Sheinbaum que el virus es habitual durante la temporada de gripe y que, aunque no existe un tratamiento específico ni una vacuna, no hay motivos de alarma en relación con este caso.
El hombre, que no tenía comorbilidades, es sospechoso de haber estado infectado con el HMPV, pero las autoridades de la Dirección de Epidemiología aún están evaluando los detalles. Kershenobich enfatizó que, aunque se confirme el diagnóstico, no se trata de un brote grave, por lo que no representa un riesgo importante para la salud pública. “Es una gripe común que ocurre en esta temporada, muchos de ustedes pudieron haberla tenido sin saberlo”, dijo el funcionario, al tiempo que resaltó la importancia de mantener cuidados generales como una buena alimentación y evitar el contacto cercano con personas infectadas.
En respuesta a la difusión de información sobre el virus, María del Rocío Baños Lara, directora del Centro de Investigación Oncológica “Una Nueva Esperanza” de la UPAEP, expresó que, aunque se han reportado casos tanto en China como en México, estos no representan una amenaza inminente. La especialista hizo un llamado a no difundir noticias alarmistas ni proveniente de fuentes no verificadas, ya que el aumento en los reportes de HMPV es más bien un reflejo de una mayor búsqueda del virus, no de un incremento en los casos.
En resumen, aunque el caso en Puebla está siendo investigado, las autoridades han dejado claro que no hay motivo para generar pánico entre la población, y se mantienen vigilantes sobre cualquier cambio en el comportamiento del virus.